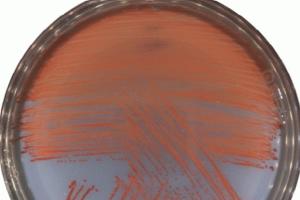

|
СіГ 25РЯ ЛѕЗгАд УтЙќЧб 2Бт СјЛѓСЖЛчКИАэМРлМКБтШЙДмРК БтСИПЁ СІБтЕЧДј ЦэЧтРЮЛчПЁ ДыЧб ПьЗСИІ РсРчПьАэ ПЉМјЛчАЧПЁ ДыЧб ИэЙщЧб СјЛѓБдИэРЛ РЬЗъ АЭРИЗЮ БтДыЧЯАэ РжДй.
СІ2Бт БтШЙДмРК БЙЛчЦэТљРЇПјШИ БшЕцСп ПЌБИАќРЛ ДмРхРИЗЮ АќЗУ РќЙЎАЁПЭ Й§СЖАш, РЏСЗ ДыЧЅ Ею РЇУЫСї ДмПј 10ИэАњ ДчПЌСї ДмПј 5Иэ Уб 15ИэРИЗЮ ЦјГаАд БИМКЕХ РќЙЎМКАњ ДыЧЅМКРЛ АэЗч АЎУс АЭРИЗЮ ЦђАЁЕШДй.
БтШЙДмРК ПЉМјЛчАЧ СјЛѓКИАэМРлМК Й§СЄБтЧбРЮ 2027Гт 4Пљ 4РЯБюСі ИэЙщЧб СјЛѓБдИэРЛ РЇЧи ЛчАЧРЧ МКАн, БЙАЁ УЅРгЙќРЇ, ШёЛ§ БдИ№, ЧЧЧи РЏЧќ ЕюРЛ УМАшРћРИЗЮ КаМЎЧи БЙАЁ ТїПјРЧ АјНФ СјЛѓСЖЛчКИАэМ ПЯМКРЛ РЇЧб НЩЕЕ РжДТ ГэРЧПЭ КаМЎРЛ ЧЯАд ЕШДй.
БшЕцСп 2Бт СјЛѓСЖЛчКИАэМРлМКБтШЙДмРхРК ЁАЧбБЙ ЛчШИПЁ ХЋ ПЕЧтРЛ ГЂФЃ ПЉМјЛчАЧРЧ УЖРњЧб СјЛѓБдИэРЛ ХыЧи ЧЧЧиРкРЧ ИэПЙИІ ШИКЙЧЯАэ, БЄЙќРЇЧб ЛчЗс МіС§Ањ КаМЎРЛ ХыЧи АДАќРћРЮ ПЊЛч КИАэМИІ РлМКЧЯЕЕЗЯ ГыЗТЧЯАкДйЁБАэ ЙрЧћДй.
РќГВЕЕДТ ОеРИЗЮ БтШЙДмРЧ ПјШАЧб ШАЕПРЛ РЇЧи УжМБРЛ ДйЧи СіПјЧв ЙцФЇРЬДй.
СІ2Бт БтШЙДм БИМКЁЄШАЕППЁ ЙпИТУч ЕЕГЛ НУБКРЛ ХыЧи СЂМіЕШ СјЛѓБдИэ НХАэ 2УЕ419АЧПЁ ДыЧи СіГ 10ПљКЮХЭ ЛчНЧСЖЛчПЁ ТјМіЧпДй.
ЖЧЧб БтШЙДмАњ ЧљЗТЧи БтШЙДмРЧ СјЛѓКИАэМРлМКПЁ ДыЧб БтУЪРкЗсПЭ ХфДы ИЖЗУПЁ РћБи СіПјЧв СиКёИІ ПЯЗсЧпДй.
ОеМ 2025Гт 5ПљКЮХЭ 11ПљБюСі АэЕюБКЙ§ШИРЧ РкЗсИІ ХыЧи ЙпАпЕШ ПЉМјЛчАЧ ШёЛ§Рк 2УЕ867Иэ Сп ПЯЕЕСіПЊ 125ИэРЧ ПЉМјЛчАЧ ШёЛ§РкПЁ ДыЧи СїБЧСЖЛчИІ ЧпРИИч, ЧтШФ СЖЛч АсАњДТ БтШЙДмАњ РЇПјШИ НЩРЧ РЧАсРЛ ХыЧи СјЛѓКИАэМПЁ ЙнПЕЕЩ ПЙСЄРЬДй.
РќГВЕЕДТ НЩЕЕРжДТ СЖЛчАЁ ЧЪПфЧб КЮКаПЁ ДыЧиМДТ БтШЙДмАњ ЧдВВ СїБЧСЖЛчИІ РќБЙРћРИЗЮ ШЎДыЧЯАэ, БЙЙцКЮПЭ АцТћУЛ, БЙАЁБтЗЯПј Ею РЏАќБтАќРЧ ПЉМјЛчАЧ АќЗУ КИСИРкЗс СЖЛчЕЕ ШЎДыЧи ШёЛ§Рк Чб КаРЬЖѓЕЕ ГѕФЁСі ОЪЕЕЗЯ УжМБРЛ ДйЧв ЙцФЇРЬДй.
БшПЕЗЯ РќГВЕЕСіЛчДТ ЁАРќЙЎМКАњ СЄФЁРћ СпИГРЛ АЎУс СІ2Бт БтШЙДм УтЙќПЁ БзЕПОШ СпОгСЄКЮПЭ ЧљРЧЧпДј РќГВЕЕРЧ АЂАэРЧ ГыЗТРЬ РЬРчИэ СЄКЮПЁМ РЬЗяСј АЭПЁ ДыЧи АЈЛчПЭ ШЏПЕРЧ ЖцРЛ ЙрШљДйЁБАэ ИЛЧпДй. РЬОю ЁАСІ2Бт БтШЙДмРЬ РлМКЧЯДТ СјЛѓСЖЛчКИАэМДТ СјЛѓБдИэ РЬПмПЁЕЕ ПЉМјЛчАЧРЧ БЙАЁ УЅРг ЙќРЇПЭ СЄКЮСЖФЁ ЛчЧзПЁ ДыЧб БЧАэАЁ ЦїЧдЕЧАэ РЏСЗСіПјАњ РЇЗЩЛчОї ЕюПЁ ДыЧб БйАЃРЬ ЕЧДТ АЭРЬБтПЁ РќГВЕЕАЁ ОеРхММ ЧдВВЧЯАэ РћБи СіПјЧЯАкДйЁБАэ АСЖЧпДй.
ЧиРЮБГРАНХЙЎ
 2025.11.26(Мі) 12:58
2025.11.26(Мі) 12:58